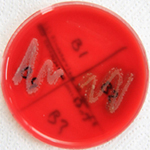
Tinglev Dyrehospital I/S

Laboratorium

Bakteriologisk undersøgelse
Tinglev Dyrehospital Stordyr har haft eget laboratorium i flere år. I starten blev det især anvendt til dyrkning af mælkeprøver. Når en ko behandles for yverbetændelse udtages en mælkeprøve som dyrkes bakteriologisk.
Dette gøres for at undgå unødig lidelse hos koen, for at sikre fødevaresikkerheden og for at minimere landmandens tab i forbindelse med koens sygdom.
For at sikre kvaliteten af mælkeprøveaflæsningen, deltager hospitaletpersonalet hvert år i en såkaldt RING-test. Hospitalet får tilsendt et antal mælkeprøver som er dyrket på et større laboratorie. Hospitalets aflæsningsresultater sammenholdes herefter med "facitlisten" fra det store laboratorie.
På hospitalets laboratorie undersøges endvidere mange gødningsprøver fra produktionsdyr.
Dels i forbindelse med sygdom men også for rutinemæssigt at holde øje med indvoldsparasitter (parasitologisk undersøgelse). Herved sikres at husdyrene behandles i fornødent omfang.

